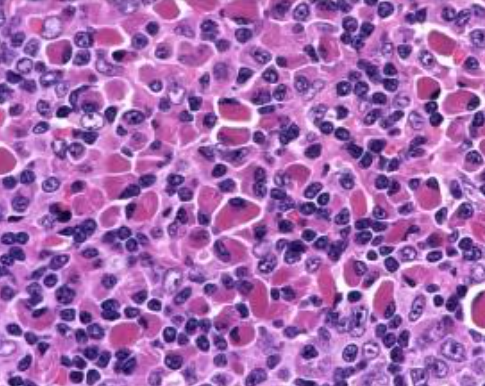
1744872881830125.png 1.png

有趣、有料、有用,肿瘤界100秒是一档利用碎片时间了解肿瘤学的科普音频,每期2~3个知识点,轻松了解肿瘤学知识,挖掘知识背后的奇闻逸事,让知识鲜活。
跟随肿瘤界,听点肿瘤学。大家好,这里是肿瘤界100s,我是主播李静。
最近,听“得到app”的陶勇老师讲眼科知识,他谈及一个病例让人印象深刻。
有位阿姨因为视物模糊辗转多家医院无果,但诊断都是惊人的相似,玻璃体浑浊,逗号,原因不明。经过常规的治疗以后总是开始起效,但后续又继续加重。
陶勇老师就意识到,这不是普通的玻璃体浑浊,病因很可能出在颅内神经系统。因为眼睛不只是一个感受光的器官,也是翻译成电信号的转换器,并通过视神经传递到颅内枕叶皮层。
陶勇老师就给这位阿姨作了眼泪检测,结果发现眼泪中的白介素10水平较高(IL-10),IL-10是一种多功能的抗炎细胞因子,通常在免疫应答过程中发挥作用。提示颅内可能存在着免疫异常,没准就是颅内存在淋巴瘤。结果他跟神经科和肿瘤专家会诊后,确诊为弥漫大B细胞淋巴瘤(DLBCL)。
弥漫大B细胞淋巴瘤这个长病名的含义是什么?而且弥漫大B在近年又提出了一种叫做双打击(doubt-hit)淋巴瘤的特异性亚型[1],化疗效果差,无论是否积极治疗,中位生存期仅存0.2~1.5 年,这个"双击淋巴瘤"又是怎么回事呢?
弥漫大B细胞淋巴瘤这个命名看起来很好理解,就是字面的意思,即分散的、大个的B细胞恶变,但深究起来估计很多人也是一知半解。
首先,我们来看看这个弥漫是什么意思。虽然弥漫大B的典型症状也有无痛性、进行性淋巴结肿大和结外肿块,但是在组织学方面不同于霍奇金淋巴瘤,后者在淋巴结中呈结节样生长,而弥漫大B细胞淋巴瘤在淋巴结或其他组织中是分散的,分布毫无规律可言,也就是说弥漫大B更具侵袭性。这也解释了弥漫大B会出现在神经系统、胃肠道、甚至几乎任何器官的原因。虽然弥漫大B的侵袭性较高,但如果及时治疗,大约三分之二的病人是可以治愈的[2]。
我们再来看看“大B”。顾名思义,这大B是指镜下异常的B细胞个头比一般的B细胞要大,具体来说就是异常B细胞的细胞核是正常的至少2倍大[3]。
弥漫大B细胞淋巴瘤
有意思的是,在上个世纪50年代,人们认为大细胞肿瘤并不是淋巴细胞来源的,治疗以氮芥和抗代谢物为主,结合相对原始的放疗,后来才意识到是B细胞起源,而且直到CHOP化疗方案以及后来利妥昔单抗的出现(R-CHOP),才改变了治疗格局,延长了弥漫大B细胞淋巴瘤患者的生命。
关于氮芥的故事可以参考我们往期的节目。
过去弥漫大B的分型主要是根据细胞来源分为:生发中心B细胞型和活化B细胞型,治疗上没有区别,即R-CHOP方案,大部分的弥漫大B患者能够延长生存期,但仍有部分患者经过R-CHOP治疗后,预后依然不佳,从而促使人们通过基因检查的微观手段,对弥漫大B细胞进行细分,并找出对R-CHOP方案不敏感以及高侵袭特性的原因。
这就引出了我们开篇提到的"双击淋巴瘤"的问题。时间关系,我们下期再来解释到底什么是“双击淋巴瘤”。
本期100s就到这里了,我是李静,感谢您的收听,我们下期见。
而且弥漫大B在近年又提出了一种叫做双打击(doubt-hit)淋巴瘤的特异性亚型: https://www.mdanderson.org/cancerwise/7-questions-about-double-hit-lymphoma--answered.h00-159464001.html
[2]虽然弥漫大B的侵袭性高,但如果及时治疗,大约三分之二的病人是可以治愈的: https://www.uptodate.com/contents/diffuse-large-b-cell-lymphoma-in-adults-beyond-the-basics
[3]具体来说就是异常B细胞的细胞核是正常的至少2倍大: https://www.chemicalbook.com/NewsInfo_22330.htm
